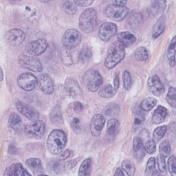
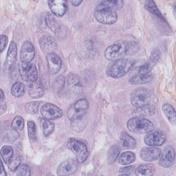
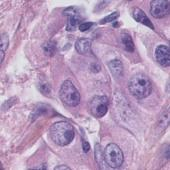

Avoiding the risk of undefined categorical labels using nearest neighbor interpolation overlooks the risk of exacerbating pixel level annotation errors in data augmentation. To simultaneously avoid these risks, the author modified convolutional neural networks data transformation functions by incorporating a modified geometric transformation function to improve the quality of augmented data by removing the reliance on nearest neighbor interpolation and integrating a mean based class filtering mechanism to handle undefined categorical labels with alternative interpolation algorithms. Experiments on semantic segmentation tasks using three medical image datasets demonstrated both qualitative and quantitative improvements with alternative interpolation algorithms.
翻译:暂无翻译